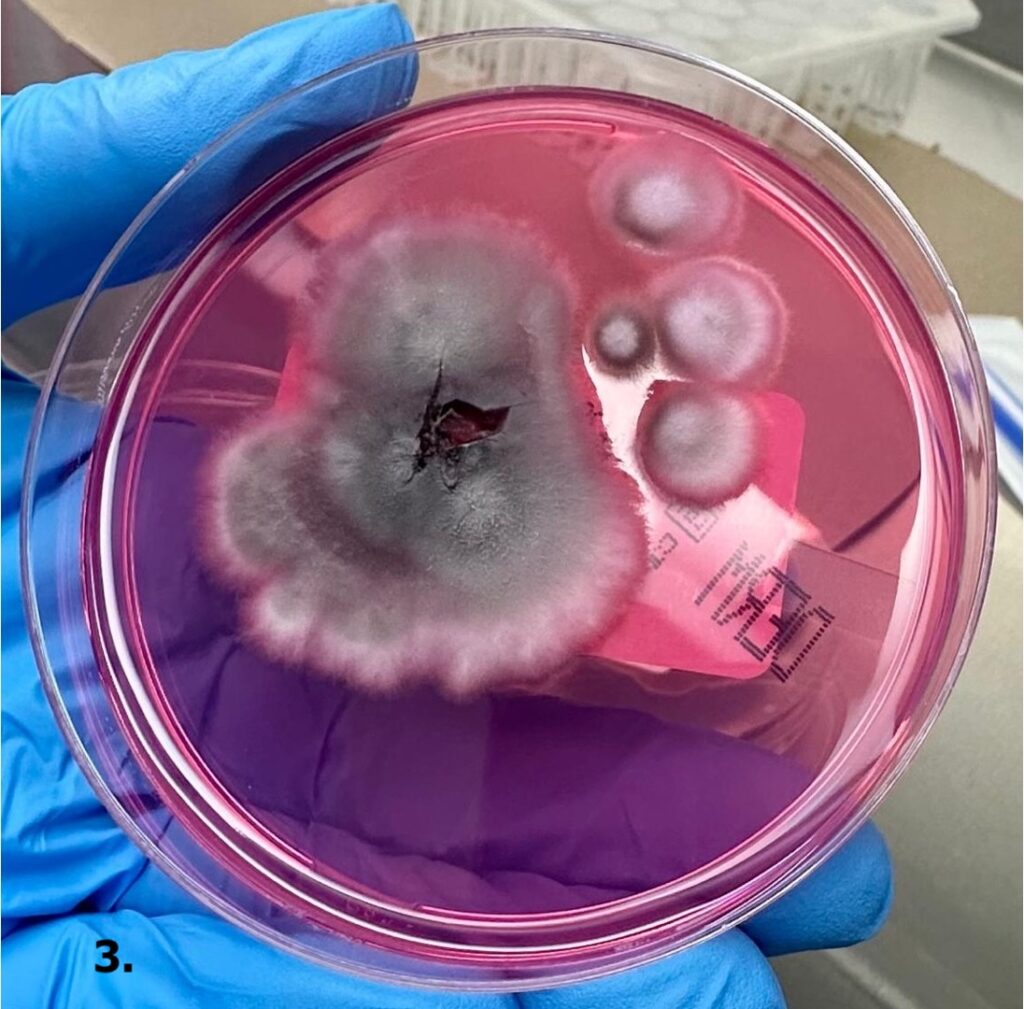
9 Dermatología Argentina 1 2026
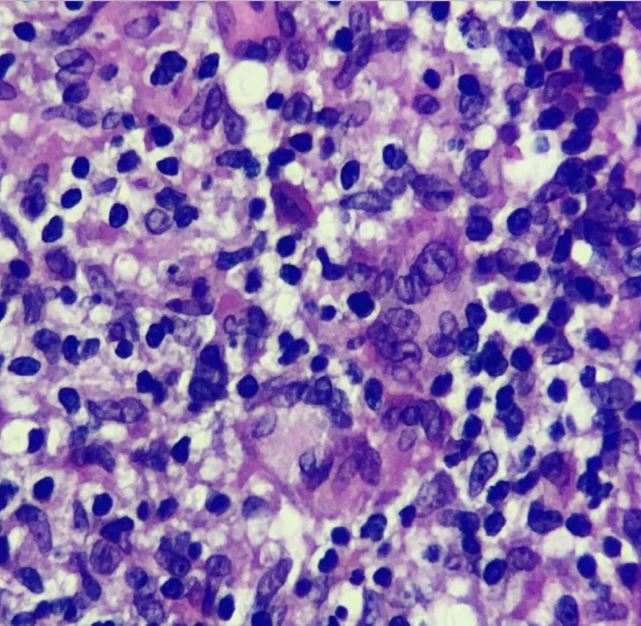
11 Dermatología Argentina 1 2026

El Nº 1 2026 de Dermatología Argentina ya se encuentra disponible online. En este número, se publican seis artículos originales, un trabajo de revisión y 10 casos clínicos
Lugones Editorial©
El número 1 enero-abril de 2026 de Dermatología Argentina, de la Sociedad Argentina de Dermatología, ya está disponible online y a continuación se presenta un breve resumen de cada uno de sus artículos.
EDUCACIÓN MÉDICA CONTINUA. Trastorno por excoriación cutánea: fisiopatológica y tratamiento
Benítez MS y col.
El trastorno por excoriación cutánea se caracteriza por el rascado repetitivo y compulsivo de la piel, lo cual produce daño tisular. Afecta más frecuentemente a mujeres y su inicio suele coincidir con la pubertad, favorecido por cambios corporales, emocionales y dermatosis como el acné. Las zonas más afectadas son la cara, los brazos y las manos (áreas de fácil acceso), con predominio del lado no dominante. Estos comportamientos se consideran adicciones conductuales ya que presentan un deseo previo a la conducta, placer durante su realización, y una repetición compulsiva y persistente del comportamiento.
Los circuitos neuronales que conectan la corteza cerebral con los ganglios basales, denominados circuitos cortico-estriatales-tálamo-corticales, desempeñan un papel clave en la formación de hábitos.
En un número considerable de casos, la consulta dermatológica constituye con frecuencia el primer punto de contacto médico de estos pacientes. Una escucha atenta y empática resulta fundamental para establecer una adecuada relación médico-paciente, facilitando el abordaje integral del caso.
La terapia cognitivo conductual busca la readaptación del paciente en los planos físico, emocional y conductual; se destaca la terapia de reversión de hábitos, que tiene como objetivo reemplazar las conductas compulsivas por otras alternativas más adaptativas.
Las guías clínicas recomiendan el uso de fármacos que actúan sobre las vías serotoninérgicas como los inhibidores selectivos de la recaptación de serotonina. Aproximadamente el 30% de los pacientes no responde, por lo que una alternativa terapéutica son los fármacos moduladores del sistema glutamatérgico: N-acetilcisteína (dosis de 1200 a 2400 mg/día) y memantina (dosis de 10 a 20 mg/día).

Circuito cortico-estriado-tálamo-cortical: hábitos, movimientos y recompensa
TRABAJO ORIGINAL. Análisis histopatológico de la citorreducción y del estadio 1 de slow Mohs tras electrocuretaje e imiquimod al 5% en carcinoma basocelular de alto riesgo: estudio prospectivo de 31 casos
El electrocuretaje (EC) y el imiquimod al 5% son terapias efectivas para el carcinoma basocelular (CBC) de bajo riesgo. En alto riesgo, el uso previo de imiquimod ha demostrado reducir el número de estadios de Mohs. No existen estudios que evalúen la combinación de EC + imiquimod al 5% con análisis histopatológico de la citorreducción y del estadio 1 de slow Mohs.
En este contexto, los autores analizaron la histopatología de la citorreducción y del estadio 1 de slow Mohs tras EC + imiquimod al 5% en CBC de alto riesgo, y compararon el número de estadios con una serie institucional sin pretratamiento.
Los autores observaron ausencia tumoral en el 87,1% (27/31; IC 95%: 69-96%), mientras que la persistencia tumoral fue del 12,9% (4/31; IC95%: 4.2-31%). En la nariz (n=15) la persistencia fue del 26,7%, mientras que en las localizaciones extranasales (n=16) fue del 0%.
La combinación EC + imiquimod al 5% como pretratamiento previo a la cirugía de slow Mohs mostró alta tasa de negatividad histopatológica, especialmente fuera de la nariz, lo cual sugiere un potencial ahorro de estadios y utilidad en contextos sin acceso a la cirugía de Mohs o con contraindicación.

Estadio 1 de slow Mohs. Se puede observar que se había tomado el tejido de citorreducción (área central) para su envío a Histopatología.
TRABAJO ORIGINAL. Síndrome de BASCULE en pediatría
Pusky DY y col.
El síndrome de BASCULE (Bier anemic spots, cyanosis and urticaria-like eruption) es una dermatosis vasomotora benigna frecuentemente subdiagnosticada. Se manifiesta por episodios transitorios desencadenados a los pocos minutos de adquirir la posición de pie, caracterizados por eritrocianosis, manchas anémicas de Bier y erupción símil urticaria (BASCULE).
Es más frecuente en los miembros inferiores, y puede acompañarse de dolor y/o prurito local e hipotensión ortostática. El diagnóstico es clínico y no existe un tratamiento específico estandarizado.
En este trabajo, los autores describen los casos clínicos de tres pacientes con diagnóstico de síndrome de BASCULE, en dos de ellas asociado taquicardia e hipotensión ortostática.
Dado que el síndrome de BASCULE es una entidad probablemente subdiagnosticada, los autores destacan la importancia de su reconocimiento clínico a fin de evitar estudios innecesarios.

A) Edema y eritema en ambas piernas asociados a manchas de Bier. B) Desaparición de signos al recostarse y elevar los miembros.
TRABAJO ORIGINAL. Prevalencia y características clínicas de farmacodermias en pacientes hospitalizados: estudio observacional transversal de 10 años en un hospital de tercer nivel en la Argentina
Abbruzzese M y col.
Las reacciones adversas a medicamentos (RAM) con manifestaciones cutáneas, mucosas y/o anexiales, denominadas farmacodermias, constituyen una de las presentaciones más frecuentes de los efectos adversos a fármacos. Se estima que entre el 10-30% de las RAM afectan la piel y que el 2-10% de los pacientes hospitalizados desarrollan lesiones cutáneas secundarias a fármacos.
En este trabajo, los autores se propusieron determinar la prevalencia de farmacodermias en pacientes hospitalizados en el Hospital Universitario Austral entre el 1º de enero de 2014 y el 31 de diciembre de 2024, y describir sus características clínicas, terapéuticas y evolutivas.
Los autores concluyeron que los antibióticos fueron los fármacos más implicados, aunque en un número considerable no se identificó la droga causal. El diagnóstico precoz podría disminuir la morbimortalidad asociada.
Este estudio resalta la necesidad de mejorar los sistemas de registro y seguimiento dermatológico en pacientes hospitalizados en quienes las farmacodermias pueden complejizar el tratamiento y la evolución.
Obtener información completa y confiable, y trabajar de forma interdisciplinaria es indispensable para avanzar hacia una mejor caracterización epidemiológica de los pacientes, optimizar su seguridad y establecer estrategias tendientes a reducir su morbimortalidad.

Reacción a fármacos con eosinofilia y síntomas sistémicos con afectación del dorso y extremidades superiores
TRABAJO ORIGINAL. Carcinoma de células de Merkel
Soliz Burgos ML y col.
El carcinoma de células de Merkel (CCM) es un carcinoma neuroendocrino cutáneo poco frecuente y muy agresivo. Afecta predominantemente a personas caucásicas, de sexo masculino, edad avanzada e inmunosuprimidas.
Su etiología está relacionada con mutaciones inducidas por la radiación ultravioleta (UV), así como con la infección por un virus oncogénico, el poliomavirus de células de Merkel (MCPyV).
Su presentación clínica típica es una lesión tumoral eritematoviolácea de rápido crecimiento en zonas fotoexpuestas; sin embargo, se han descripto otras presentaciones menos habituales. La histopatología y la inmunohistoquímica confirman el diagnóstico.
Las opciones de tratamiento se han ampliado en las últimas décadas mejorando notablemente el pronóstico en la enfermedad avanzada con una combinación de cirugía, radiación e inmunoterapia sistémica.

Lesión tumoral a nivel cervical anterior
TRABAJO ORIGINAL. Uso de dupilumab en pacientes con dermatitis atópica y comorbilidades habitualmente excluidas de los ensayos clínicos
Nougues M y col.
Los ensayos clínicos controlados constituyen el estándar para evaluar la eficacia y la seguridad de los fármacos; sin embargo, sus estrictos criterios de exclusión limitan la representatividad de la población atendida en la práctica clínica habitual.
En este contexto, las terapias biológicas han mejorado de manera sustancial el control de la dermatitis atópica (DA) en pacientes refractarios a tratamientos convencionales o con contraindicaciones para su uso. Dupilumab, un anticuerpo monoclonal dirigido contra la vía IL-4/IL-13, ha demostrado eficacia y seguridad en distintos escenarios clínicos.
En este trabajo, los autores presentan una serie de 10 pacientes con DA moderada a severa y comorbilidades relevantes, incluyendo neoplasias activas, infección por el virus de la inmunodeficiencia humana, tuberculosis, hepatitis B y lactancia.
Según sus resultados, todos los pacientes presentaron una mejoría clínica significativa del eczema y del prurito, sin exacerbación de las comorbilidades de base ni aparición de eventos adversos graves.
Esta experiencia del mundo real respalda el uso de dupilumab en poblaciones diversas y sugiere un potencial beneficio de futuras terapias dirigidas contra IL-13 en escenarios clínicos complejos.

Marcada mejoría clínica y persistencia de hiperpigmentación posinflamatoria residual tras un año de tratamiento con dupilumab
TRABAJO ORIGINAL. Acné fulminans inducido por isotretinoína
Rabanal F y col.
El acné fulminans (AF) es una forma clínica severa de acné inflamatorio caracterizado por un brote súbito y doloroso de nódulos, pápulas, pústulas hemorrágicas y úlceras con costras en la cara y el tronco superior. Puede o no estar asociado a síntomas sistémicos y alteraciones en el laboratorio. Afecta más frecuentemente a adolescentes de sexo masculino con antecedente de acné.
En este artículo, los autores presentan cinco casos de AF inducido por isotretinoína, en su mayoría sin síntomas sistémicos asociados. En todos los casos, el diagnóstico se estableció a partir de los hallazgos clínicos, los antecedentes del paciente y los exámenes complementarios.
Todos los pacientes recibieron tratamiento sistémico; sin embargo, el manejo terapéutico se individualizó según el criterio del médico tratante y la disponibilidad de recursos. En la actualidad no existen esquemas terapéuticos completamente estandarizados para esta entidad.

Pápulas y nódulos eritematosos cubiertos por costras necróticas en el tórax
TRABAJO DE REVISIÓN. Abordaje integral de la uña en pinza: causas, diagnóstico y estrategias terapéuticas
Aguilar Molina H y col.
La uña en pinza es una onicopatía caracterizada por la sobrecurvatura transversal de la uña, lo que provoca el pinzamiento del lecho ungueal. El primer dedo del pie es el más frecuentemente afectado.
Esta condición puede asociarse a dolor, que varía de leve a severo, y a un engrosamiento de la lámina ungueal que dificulta su corte.
El abordaje terapéutico de la uña en pinza aún es un reto dado que ninguna estrategia demostró resultados definitivos ni ausencia de recurrencia. Los tratamientos conservadores pueden ofrecer alivio sintomático en casos leves, pero su eficacia suele ser transitoria. Las técnicas quirúrgicas, aunque más resolutivas, no están exentas de complicaciones y recidivas, lo que obliga a individualizar la elección del procedimiento según la severidad de la deformidad, el grado de dolor y las expectativas del paciente.
En este sentido, los autores concluyen que se requieren investigaciones comparativas y de seguimiento a largo plazo que permitan establecer protocolos terapéuticos más efectivos y duraderos.

Uña en pinza secundaria a onicomicosis
CASO CLÍNICO. Síndrome KID con mutación p.Asp50Asn en el GJB2
Nougues M y col.
El síndrome KID (keratitis, ichthyosis, deafness; queratitis, ictiosis y sordera) es una genodermatosis poco frecuente, de herencia autosómica dominante, causada por mutaciones en el gen GJB2 que codifica la conexina 26.
Los autores presentan el caso de un paciente con diagnóstico clínico en la infancia, caracterizado por eritroqueratodermia, queratitis vascularizante progresiva e hipoacusia neurosensorial congénita. El estudio genético confirmó la mutación p.Asp50Asn en el GJB2, la variante patogénica más comúnmente asociada a esta entidad.
Asimismo, se analizaron las manifestaciones clínicas y complicaciones del cuadro, y se discutieron los aspectos fisiopatológicos, genéticos y terapéuticos, incluyendo tratamientos clásicos y nuevas estrategias moleculares en investigación.

Queratodermia plantar con engrosamiento difuso, fisuras y placas hiperqueratósicas
CASO CLÍNICO. Liquen plano hipertrófico en un paciente pediátrico
Babbini YS y col.
El liquen plano hipertrófico (LPH) es una variante clínica del liquen plano (LP) infrecuente en la edad pediátrica caracterizado por la presencia de pápulas poligonales y placas hiperqueratósicas de aspecto verrugoso, de color marrón-violáceo o grisáceo, pruriginosas, distribuidas en forma simétrica principalmente en los miembros inferiores.
Su diagnóstico es clínico y se confirma mediante el estudio histopatológico. Actualmente no existe un tratamiento estandarizado en pediatría.
Los autores presentan el caso de un paciente de 11 años, previamente sano, con diagnóstico clínico e histopatológico de LPH que presentó buena respuesta al tratamiento con fototerapia UVB de banda angosta y corticoides sistémicos.

Placas hipertróficas de coloración gris-violácea, brillantes, con bordes eritematosos
CASO CLÍNICO. Paciente pediátrico con esporotricosis de localización inusual
Cano Valencia AM y col.
La esporotricosis cutánea es una infección micótica causada por el complejo de hongos dimórficos Sporothrix schenckii. Clásicamente se ha descrito en hombres con ocupaciones relacionadas con la jardinería o la agricultura, sin embargo, se ha observado un aumento de su incidencia en niños, siendo la cara y las extremidades superiores los lugares más comúnmente afectados.
En este artículo, los autores presentan el caso clínico de una esporotricosis cutánea pediátrica con una localización atípica. Asimismo, describen algunos hallazgos dermatoscópicos y el uso de la crioterapia asociada al itraconazol con buenos resultados clínicos.
Cultivo en agar Sabouraud dextrosa con colonias glabras, húmedas, de color crema y con crecimiento radial
CASO CLÍNICO. Angioqueratoma circunscripto: más allá de una lesión benigna
Franco Y y col.
Los angioqueratomas son lesiones vasculares benignas bien delimitadas, que consisten en dilatación vascular superficial e hiperqueratosis. Se reconocen cinco variantes (con la excepción del angioqueratoma circunscripto que representa una malformación capilar-linfática o capilar) que son consecuencia de la dilatación ectásica de los vasos preexistentes en la dermis papilar.
Clínicamente se presentan como pápulas hiperqueratósicas verrugosas de color rojo a negro-azulado. El diagnóstico se basa en la presentación clínica, la dermatoscopia y la histopatología.
Los autores presentan el caso de un varón de 25 años con presencia de pápulas hiperqueratósicas violáceo-negruzcas en el pie derecho desde el nacimiento.

Tumoración hiperqueratósica violácea-negruzca sobre base eritematosa en la cara lateral externa del dorso del pie derecho
CASO CLÍNICO. Leishmaniasis mucocutánea de aspecto lupoide
Zuleta P y col.
La leishmaniasis es una zoonosis causada por protozoos intracelulares del género Leishmania spp.
En este trabajo, los autores presentan el caso de una paciente de 41 años, oriunda de Tucumán, con una forma poco frecuente de leishmaniasis mucocutánea (LMC). La clínica mostró placas infiltradas con tubérculos centrofaciales y compromiso mucoso. La histología reveló un infiltrado inflamatorio granulomatoso y la PCR confirmó Leishmania spp.
Se indicó tratamiento con antimoniato de meglumina y pentoxifilina, con reducción posológica por efectos adversos y evolución clínica favorable.
Los autores concluyen que este caso resalta la importancia de considerar variantes crónicas lupoides en el diagnóstico diferencial de la LMC y la necesidad de una correlación clínico-histopatológica.
Infiltrado inflamatorio constituido por células gigantes multinucleadas e histiocitos conformando granulomas (HyE, 400x)
CASO CLÍNICO. Márgenes falsos positivos durante la cirugía micrográfica de Mohs de un carcinoma basocelular nodular en paciente con tricoepiteliomas múltiples
Reggiardo A y col.
Los tricoepiteliomas y el carcinoma basocelular comparten características clínicas e histopatológicas que pueden confundirse con facilidad y conducir a un error diagnóstico y, por lo tanto, terapéutico.
Se presenta el caso de una paciente con tricoepiteliomas múltiples y carcinoma basocelular en la zona facial tratada mediante cirugía micrográfica de Mohs.
Durante el procedimiento, se enfrentaron dificultades en el diagnóstico dermopatológico, lo que se requirió procesar la pieza en diferido mediante la técnica convencional para confirmar el diagnóstico.

Múltiples lesiones clínicamente compatibles con tricoepiteliomas, una de ellas se destaca por ser una lesión tumoral, con superficie lisa, brillo perlado, sospechosa clínicamente de carcinoma basocelular
CASO CLÍNICO. Melanoma de la mucosa nasal: una entidad poco frecuente
Zambrano C y col.
El melanoma mucoso (MM) es una variedad rara y muy agresiva de melanoma que representa menos del 1% de estas neoplasias. Debido a su localización en áreas de difícil acceso, generalmente el diagnóstico y el tratamiento resultan más complicados.
Se presenta el caso de un paciente de 73 años que consultó por epistaxis, obstrucción nasal izquierda, proptosis, epífora y diplopía ipsilateral de 2 meses de evolución, con evidencia de lesión tumoral en la fosa nasal izquierda compatible con MM. Inició tratamiento con pembrolizumab, con buena respuesta.

Tumoración negruzca en la fosa nasal izquierda
CASO CLÍNICO. Dermatomiositis paraneoplásica con histopatología compatible con dermatosis neutrofílica tipo Sweet
Sívori ME y col.
La dermatomiositis (DM) es una miopatía inflamatoria de origen desconocido que presenta una histología cutánea generalmente inespecífica. Sin embargo, se han registrado algunos casos de DM con histopatología en la que se observa un infiltrado neutrofílico difuso en la dermis.
En este artículo, los autores presentan el caso de una paciente con DM paraneoplásica cuya biopsia cutánea reveló características compatibles con una dermatosis neutrofílica tipo Sweet.

Pápulas de Gottron en el dorso de las articulaciones metacarpofalángicas e interfalángicas proximales
CASO CLÍNICO. Fístula cutánea tardía secundaria a material de ligadura de safenectomía
García Verdú E y col.
Se presenta el caso de una paciente con una fístula cutánea en el muslo izquierdo secundaria a material de sutura no absorbible utilizado en una safenectomía previa, diagnosticada inicialmente como fístula secundaria a hidradenitis supurativa.
El hallazgo ecográfico y la confirmación histopatológica permitieron establecer el diagnóstico definitivo.
Este caso destaca la importancia del diagnóstico diferencial en lesiones fistulosas solitarias, especialmente en pacientes con antecedentes quirúrgicos.

Pieza de extirpación quirúrgica hasta el plano subcutáneo con material quirúrgico de sutura embebido en la hipodermis
CASO CLÍNICO. Elastólisis de la dermis papilar similar a pseudoxantoma elástico
Coba B y col.
La elastólisis dérmica papilar similar a pseudoxantoma elástico (EDPSP) es parte de un conjunto de enfermedades del sistema fibroelástico de la dermis que se caracteriza por la disminución o pérdida de las fibras elásticas a sus diferentes niveles, tanto papilar como reticular.
Se manifiesta como lesiones cutáneas localizadas en la cara posterior y los laterales del cuello, las caras flexoras de los antebrazos, las axilas y el abdomen inferior que clínicamente se asemejan al pseudoxantoma elástico (PXE). La edad de presentación, los hallazgos histopatológicos y la afectación sistémica permiten diferenciar estas dos enfermedades.
En este artículo, los autores comunican el caso de una paciente de 70 años con lesiones y localizaciones típicas.

Pápulas agrupadas en forma de empedrado localizadas en el cuello posterior
Acceda aquí al número completo de Dermatología Argentina Nº 1 2026









